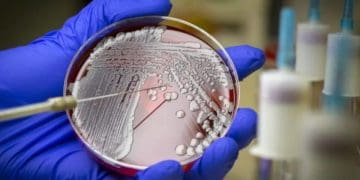
Штучний інтелект допоміг вченим відкрити новий надпотужний антибіотик

Як повідомляє ВВС, вчені взяли тисячі ліків із точно відомою хімічною структурою і вручну протестували їх на Acinetobacter baumannii.
Це одна із трьох супербактерій, які ВООЗ визначила як «критичну» загрозу. Вона здатна викликати менінгіт, пневмонію, зараження ран, інфекції кровотоку та урологічні інфекції.
На основі результатів штучний інтелект створив список із 6680 з’єднань, ефективність яких була невідома, а потім остаточний список із 240 позицій. І це за півтори години.
Подальші лабораторні випробування допомогли вченим виявити 9 потенційних антибіотиків